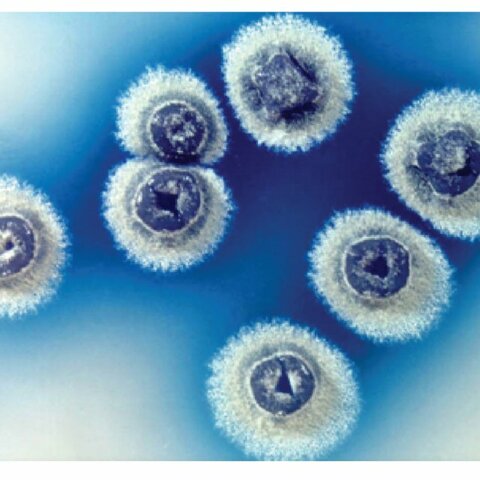
N-bromosuccinimida

-
 Descubrimiento del proceso de la fermentación por parte de Louis Pasteur
Descubrimiento del proceso de la fermentación por parte de Louis Pasteur -
 Se desarrolló un fermentador para la producción de acetona por Chain Weizmann
Se desarrolló un fermentador para la producción de acetona por Chain Weizmann -
 Producción comercial de ácido cítrico en USA
Producción comercial de ácido cítrico en USA -
 Se utiliza por primera vez un biorreactor para la producción de levaduras
Se utiliza por primera vez un biorreactor para la producción de levaduras -
 Producción de penicilina por fermentación
Producción de penicilina por fermentación -
 Beeze y Liebmann utilizaron el primer fermentador de gran escala para la producción de levaduras
Beeze y Liebmann utilizaron el primer fermentador de gran escala para la producción de levaduras -
 Se diseñan los primeros fermentadores aéreos
Se diseñan los primeros fermentadores aéreos -
Se utiliza la levadura de Streptomyces para la creación de N-bromosuccinimida
Se utiliza la levadura de Streptomyces para la creación de N-bromosuccinimida -
 Más de 100 nuevas vacunas y medicinas producidas mediante bioprocesos
Más de 100 nuevas vacunas y medicinas producidas mediante bioprocesos -
 Inicia la comercialización de los primeros biorreactores, con contadores de colonias y autoclaves
Inicia la comercialización de los primeros biorreactores, con contadores de colonias y autoclaves -
 Se comienzan a usar los biorreactores de columna
Se comienzan a usar los biorreactores de columna -
 Basada en la utilización de microorganismos recombinantes, de sustancias nuevas nunca producidas antes por esa vía como la insulina, hormona de crecimiento, interferón y otras de muy reciente aparición en el mercado de productos relacionados con el área de la salud
Basada en la utilización de microorganismos recombinantes, de sustancias nuevas nunca producidas antes por esa vía como la insulina, hormona de crecimiento, interferón y otras de muy reciente aparición en el mercado de productos relacionados con el área de la salud -
 Aparecen los modelos pequeños de biorreactores para cultivo de células, denominados como biorreactor de mesa
Aparecen los modelos pequeños de biorreactores para cultivo de células, denominados como biorreactor de mesa -
 Se inicia el uso de biorreactores Fed-Batch
Se inicia el uso de biorreactores Fed-Batch -
 La NBS diseña los primeros muestreadores microbiológicos para la esterilidad de biorreactores
La NBS diseña los primeros muestreadores microbiológicos para la esterilidad de biorreactores -
 NBS presenta los primeros fermentadores modulares a gran escala del mundo.
NBS presenta los primeros fermentadores modulares a gran escala del mundo.
Looking for a timeline maker?
Create timelines for projects, roadmaps, history, lessons, legal cases, and stories with Timetoast. Timetoast is a timeline maker for work, school, research, and stories.